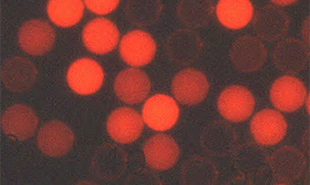
Flow-Cytometry-Beads Flow-Cytometry-Beads

Search
Search
Thermo Scientific™ 微粒产品,超过50 年的创新技术设计和生产应用经验,提供20nm 至2000μm 的广泛粒径,可溯源至美国国家标准品与技术研究院(NIST),为全球知名科研院校、制药机构、诊断实验室和精准仪器制造商提供专业的仪器校准、颗粒分析、质控计数、效能研究、系统评估、诊断研发等解决方案。
赛默飞 550 多款Thermo Scientific™ 微粒产品,包括 NIST 溯源的尺寸标准微球(DUKE 微球)、计数质控微粒、染色微粒、荧光微粒、IVD乳胶微粒和专业微粒,即日起所有用户即可享受 6.5折特价优惠,更有满赠好礼等您来选!更有新用户推荐奖励,期待您的参与!
促销时间:2025年9月1日-10月30日
满赠好礼:

单笔订单金额满 4000 元,赠沃品气传导运动蓝牙耳机或同价值礼品

单笔订单金额满 8000 元,赠HP蓝牙无线双模键盘或同价值礼品
NIST 溯源尺寸标准粒子(DUKE 粒子)
NIST Traceble Size Standards particle (DUKE particle)
可溯源至美国标准品与技术研究院(NIST)标准度量单位,有聚苯乙烯和玻璃两种材质,标称直径覆盖20nm-2000μm,适用于尺寸测量仪的研发、标准化与验证、光学和电子显微镜测定、光散射研究、胶质系统研究、半导体 SISS 系统校准等。
可溯源至美国标准品与技术研究院(NIST)标准参考物质(SRM),标称直径在100nm-100μm, 适用于气体或液体微粒计数仪的校准、注射类药物与眼药水生产商 USP 中期验证、饮用水质量优化等。
流式细胞仪的校准微粒,包含488和633校直微粒。
ChromoSphere™ 染色微粒
ChromoSphere™ Dyed Beads
采用 Color-Rich 内部深度染色工艺,直径分布于50μm 至 500μm,有红色和黑色可选,可与背景材料形成强烈的对比与可见度。
Fluoro-Max 荧光微粒
Fluoro-Max Fluorescent Particle
采用专有的 Firefli 内部染色工艺,可避免染料在液体中渗滤,有绿色、红色和蓝色可选,适用于优化传统显微镜分析功能、污染控制的定性和定量测定、流体追踪、过滤测试和孔径评估等。
直径覆盖0.03μm 至222μm,应用于过滤系统评估、光散射研究、流体动力学研究、气雾剂微粒生成、分散研究、烟雾探测等科研领域,但不适用于仪器校准或诊断试剂领域。
本次活动最终解释权由赛默飞世尔科技(中国)有限公司所有